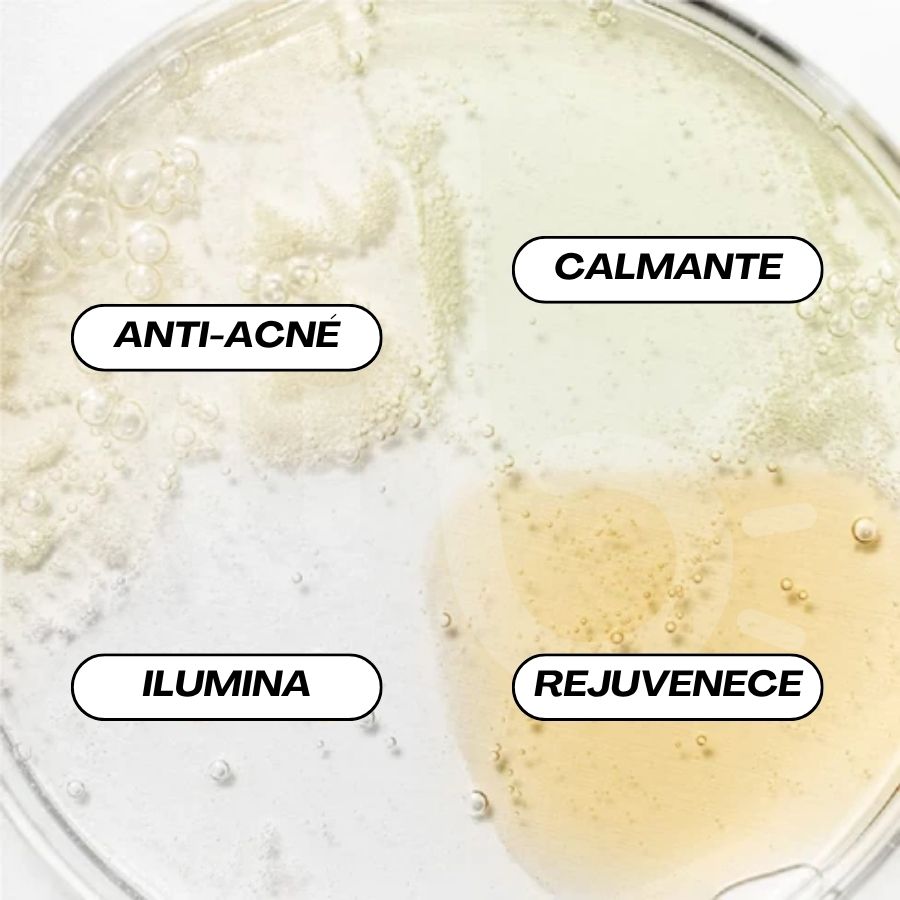

El Kit de Descubrimiento Hanbang de Beauty of Joseon reúne en un solo set los cuatro sueros icónicos de la marca, inspirados en la medicina herbal coreana. Esta colección en tamaño mini permite probar cada fórmula y personalizar la rutina según las necesidades específicas de la piel. Es ideal para quienes desean iniciarse en el cuidado facial coreano original sin comprometerse desde el inicio con los tamaños completos.
Cada uno de los serums está formulado con ingredientes tradicionales de la cosmética hanbang, altamente valorados por sus propiedades dermatológicas. El Serum Calmante combina té verde y pantenol para calmar y desinflamar la piel sensible. El Serum Luminoso mezcla propóleo con niacinamida, ideal para tratar imperfecciones, controlar el acné y mejorar el tono. El Serum Glow Deep incluye arroz y alfa-arbutina, enfocado en aclarar manchas y unificar la pigmentación. Por último, el Serum Revive combina ginseng y mucina de caracol, con acción antiarrugas y revitalizante, ideal para piel madura o apagada.
Aplicar una pequeña cantidad de uno o varios serums según las necesidades de la piel, después del tónico y antes de la crema hidratante. Pueden usarse en capas o alternarse en distintos momentos del día. Este kit de 4 x 10 ml es perfecto para todo tipo de piel, incluyendo pieles sensibles, mixtas o con preocupaciones como acné, manchas, textura irregular o signos de envejecimiento. Ideal para quienes desean explorar el mundo del skincare coreano tradicional con fórmulas seguras, efectivas y multifuncionales.

Valoraciones
No hay valoraciones aún.